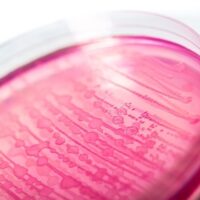

UnitedHealth Group reported on Thursday that it earned less than expected this past quarter, citing higher medical costs and pressure on its insurance division at a time when the …
We’ve all heard the virtues of protein powder for satisfying cravings and shedding unwanted weight. But there’s another nutritional powder that is gaining attention lately among regular folks (read: …
CLICK HERE to view the AMA Episode. In this AMA, Jujimufu highlights the importance of active recovery for overall health. He recommends 10-minute walks after meals to aid digestion, …
Capping ten years of work to stem the tide of nearsightedness, David Berntsen, Golden-Golden Professor of Optometry and chair of Clinical Sciences at the University of Houston College of …
You may think of chocolate truffles as being a fancy (and pricey) sweet treat that’s meant for special occasions. But whipping up chocolate truffles at home couldn’t be simpler …
Attention Cathe Live subscribers, Thursday, January 16, 2025, at 9:30 am EST, we’ll be doing “Boxing HIIT 2” LIVE! This high-energy express workout focuses specifically on boxing. You’ll have …
Nobody wants to share a day on the water with E. coli. The bacteria is a sure sign of fecal contamination, which is washed into waterways from farm fields …
Are you looking to take your martial arts school to the next level? Great! But how do you actually do it? Check out The Satori Masters Podcast from Kovar …
Starting Strength Coach Steve Ross explains how paused squats can help fix common squat errors like getting onto your toes, losing thoracic extension, and knee slide. Source link
In this episode, you’ll get to explore cutting-edge strategies and science-backed insights to help you recover faster, build strength, and make smarter health decisions. You’ll start by discovering some …